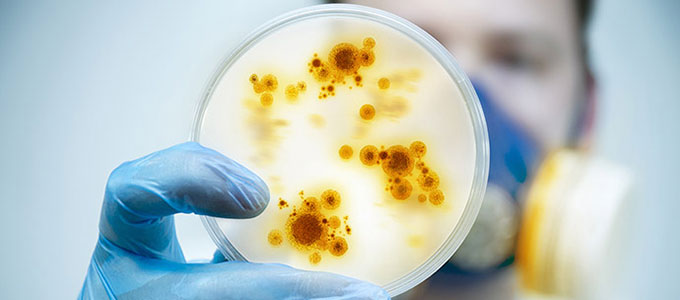

Tout désinfectant est utile dans la lutte contre les pathogènes responsables de maladies. Incontournables dans le cadre d'une démarche HACCP, les produits désinfectants sont recommandés pour un nettoyage efficace. Ils réduisent la prolifération des micro-organismes en tous genres présents sur les poignées de portes, les sanitaires, le sols et les murs.
Le point sur les micro organismes et bactéries
Les micro-organismes (microbes) sont des êtres microscopiques vivants. Ils prolifèrent et se multiplient à température ambiante. Leur colonies doublent toutes les vingt minutes et il ne faut que 24 heures pour générer une colonie de 8 millions de bactéries. Ces microbes peuvent résider sur des supports vivants ou inertes tel que les poignées, les tables, vêtements, les chaussures, les cheveux, la peau, les aliments, les animaux… 80% des maladies infectieuses se propageraient par les mains (grippes, bronchites, gastroentérites…)
Restauration : hygiène et désinfection pour éviter les contaminations
Certaines de ces bactéries (salmonelle, listéria, staphylocoque…) sont responsables d'intoxications alimentaires. On parle alors de toxi-infection. Elles surviennent après ingestion de produits contaminés par ces germes. La contamination de ces produits peut intervenir pendant leur préparation ou leur entreposage. La mauvaise conservation ou le manque d'hygiène peuvent aussi être des facteurs déclenchants. 200 000 Français par an seraient atteints de maladies d'origine alimentaire.
Tous les secteurs d'activités ont leur désinfectant

Si le domaine de la restauration est extrêmement sensible aux bactéries, les lieux dits « de passage » ou à forte affluence, les milieux exposés aux maladies ou de la petite enfance, sont particulièrement sensibles et nécessitent une hygiène sans faille afin d'enrayer la prolifération des microbes et bactéries. Voici une liste non exhaustive des secteurs concernés par la désinfection :
- Mairies, établissements publics et collectivités.
- Entreprises privées, industries, bureaux, laboratoires.
- Écoles, maisons de retraite, crèches.
- Restaurants, professionnels de la restauration.
- Hôtels, campings.
- Centres sportifs, piscines.
Besoins spécifiques et critères de choix des professionnels
Outre les bienfaits direct que procure la désinfection en terme de lutte contre les microbes et bactéries, en milieu professionnel la désinfection est un facteur rassurant pour les clients et employés. La garantie d'une désinfection efficace sera donc recherchée afin de répondre aux normes exigées dans les plans d'hygiène.
Selon les normes en vigueur, un désinfectant doit réduire de 5 log (réduction logarithmique) le nombre de bactéries, soit une élimination de 99,999%. Il faut 10 minutes aux solutions liquides pour tuer les bactéries végétatives. Les spores bactériens sont plus résistants et nécessite un temps de contact bien plus long. Pour être efficace, il convient de désinfecter après avoir nettoyé les surfaces.
La désinfection est imposée par les protocoles HACCP (Hazard Analysis Critical Control Points). La rationalisation et la centralisation des achats peuvent aussi être prises en considération et peuvent être des éléments décisifs dans l'acte d'achat. Le choix de produits simples et multi usages peut permettre de gagner en productivité.
Quel désinfectant pour quelle surface et comment l'utiliser ?

L'univers de la désinfection est large et les produits nombreux. Voici les familles de surfaces qui peuvent être désinfectées.
- Désinfectant pour les mains : savon pour les mains, gel hydroalcoolique ou savon antiseptique adaptés aux milieux médicalisés et collectivités.
- Désinfectant toutes surfaces : eau de javel, détergents avec javel, également indiqués pour les poubelles et les vide-ordures.
- Spécial surfaces alimentaires : détergents répondants aux normes HACCP, destinés aux cuisines de restauration collective ou hôtellerie.
- Spécial sanitaires : gel WC avec javel, lingettes sanitaines, pour toutes les toilettes recevant du public.
Les principaux conditionnements des désinfectants
Les vaporisateurs

Le conditionnement idéal pour une désinfection facile et rapide des surfaces. Son utilisation s'accompagne généralement d'une lingette microfibre afin de frotter la surface traitée. Les vaporisateurs peuvent contenir un désinfectant standard, mousse pour une meilleure adhérence aux parois, responsable ou désodorisant.
Les bidons, bouteilles ou flacons

D'une contenance échelonnée entre 500 ml et 6 litres (et jusqu'à 20 kg chez Vigor), les flacons et autres bidons répondent à des besoins importants en produits de désinfection. Facilement stockables, ces détergents ont une durée de vie toutefois limitée, il est donc important de les utiliser rapidement après achat afin de bénéficier de leurs effets nettoyants avant que ceux-ci ne s'étiolent.
Les lingettes

Les lingettes désinfectantes représentent la facilité d'utilisation. Nul besoin d'eau ou de matériel, ces lingettes - constituées en fibres intissées et imbibées de produit désinfectant vous permettront de nettoyer vos surfaces rapidement. Seul inconvénient, ces chiffons jetables ne sont pas recyclables et s'ajouteront inexorablement aux déchets ménagers…
Particularités des produits disponibles sur notre site
Notez que certains produits sont « 2 en 1 »
- Désinfection des sols + des surfaces
- Désinfection des mains + des surfaces.
Ou à action « 2 en 1 » :
- Désinfectant + nettoyant
- Désinfectant + dégraissant
- Désinfectant + détartrant
- Désinfectant + désodorisant/surodorant
Utilisez les biocides avec précaution. Avant toute utilisation, lisez l'étiquette et les informations concernant le produit. Ces informations vous sont donnés à titre d'information, ils n'engagent en rien la responsabilité de Bernard.
© Bernard | 20 octobre 2016


















